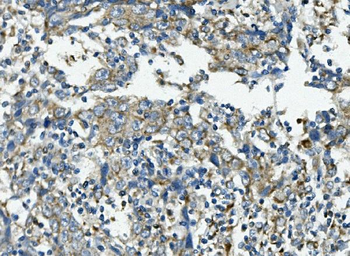
VPS4B/MIG1 Rabbit Polyclonal Antibody

You have no items in your shopping cart.
Human VPS4B Protein
SKU: orb429219
Description
Images & Validation
−
| Application Notes |
|---|
Key Properties
−| Source | E.coli |
|---|---|
| Protein Sequence | MGSSHHHHHH SSGLVPRGSH MGSHMSSTSP NLQKAIDLAS KAAQEDKAGN YEEALQLYQH AVQYFLHVVK YEAQGDKAKQ SIRAKCTEYL DRAEKLKEYL KNKEKKAQKP VKEGQPSPAD EKGNDSDGEG ESDDPEKKKL QNQLQGAIVI ERPNVKWSDV AGLEGAKEAL KEAVILPIKF PHLFTGKRTP WRGILLFGPP GTGKSYLAKA VATEANNSTF FSISSSDLVS KWLGESEKLV KNLFQLAREN KPSIIFIDEI DSLCGSRSEN ESEAARRIKT EFLVQMQGVG VDNDGILVLG ATNIPWVLDS AIRRRFEKRI YIPLPEPHAR AAMFKLHLGT TQNSLTEADF RELGRKTDGY SGADISIIVR DALMQPVRKV QSATHFKKVR GPSRADPNHL VDDLLTPCSP GDPGAIEMTW MDVPGDKLLE PVVSMSDMLR SLSNTKPTVN EHDLLKLKKF TEDFGQEG |
| Purity | Greater than 90% as determined by SDS-PAGE. |
Storage & Handling
−| Storage | Stability: Store at 4°C if entire vial will be used within 2-4 weeks. Store, frozen at -20°C for longer periods of time. For long term storage it is recommended to add a carrier protein (0.1% HSA or BSA).Avoid multiple freeze-thaw cycles |
|---|---|
| Form/Appearance | Sterile Filtered colorless solution. |
| Buffer/Preservatives | VPS4B protein solution (0.25mg/ml) containing 20mM Tris-HCl buffer (pH 8.0), 0.15M NaCl, 30% glycerol, 1mM DTT. |
| Expiration Date | 6 months from date of receipt. |
| Disclaimer | For research use only |
Alternative Names
−Vacuolar Protein Sorting 4 Homolog B (S. Cerevisiae), SKD1, Suppressor Of K+ Transport Defect 1, Cell Migration-Inducing Gene 1 Protein, Suppressor Of K(+) Transport Growth Defect 1,Vacuolar Protein Sorting 4B (Yeast), SKD1B, PS4-2, Cell Migration-Inducing 1, Vacuolar Protein Sorting 4B, Vacuolar Protein Sorting-Associated Protein 4B, EC 3.6.4.6, VPS42, Protein SKD1.
Similar Products
−VPS4B/MIG1 Rabbit Polyclonal Antibody [orb654387]
ELISA, FC, IHC, WB
Human, Mouse, Rat
Rabbit
Polyclonal
Unconjugated
100 μgVPS4B Rabbit Polyclonal Antibody [orb2953344]
ELISA, IHC, WB
Human
Rabbit
Polyclonal
Unconjugated
50 μg, 100 μgRecombinant Human VPS4B Protein, N-His [orb2965253]
ELISA, SDS-PAGE, WB
>90% as determined by SDS-PAGE.
36.25 kDa
1 mg, 50 μg, 100 μg

Quality Guarantee
Explore bioreagents carefree to elevate your research. All our products are rigorously tested for performance. If a product does not perform as described on its datasheet, our scientific support team will provide expert troubleshooting, a prompt replacement, or a refund. For full details, please see our Terms & Conditions and Buying Guide. Contact us at support@biorbyt.com.
Documents Download
Datasheet
Product Information
Request a Document
Protocol Information
Human VPS4B Protein (orb429219)
Based on 0 reviews
Participating in our Biorbyt product reviews program enables you to support fellow scientists by sharing your firsthand experience with our products.
Login to Submit a Review